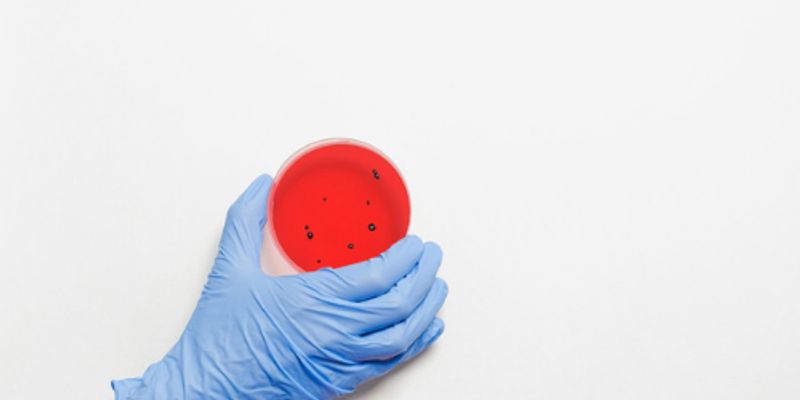

Staphylococcus (Staph Infection)
Staphylococcus is a group of more than 30 types of bacteria, some of which can cause infection and disease in humans. Most infections are caused by Staphylococcus aureus, which spreads between people through direct contact, droplets and aerosols, or touching contaminated objects. Though usually harmless, staph bacteria can lead serious, life-threatening symptoms should the infection enter the bloodstream.
What's Popular in Staphylococcus (Staph Infection)
-
FEB 16, 2025MicrobiologyBacterial pathogens can cause serious infections. So many of them are becoming resistant to the effects of antibiotics t ...Written By: Carmen LeitchMAR 08, 2024MicrobiologyTens of thousands of people die from antibiotic resistant infections very year, and these pathogenic microbes present a ...Written By: Carmen LeitchNOV 28, 2023Cell & Molecular BiologyScientists have discovered that a very common microbe that grows in many places, including human skin, can directly caus ...Written By: Carmen LeitchJAN 29, 2023MicrobiologyWe share the world, and our bodies with bacteria. Many of those microbes are harmless or even beneficial, while some can ...Written By: Carmen LeitchDEC 09, 2022Clinical & Molecular DXLabroots’ virtual events are a fantastic way to network and learn about the work of other researchers in your fiel ...Written By: Laurence Tognetti, MSc
FEB 16, 2025
Microbiology
Bacterial pathogens can cause serious infections. So many of them are becoming resistant to the effects of antibiotics t
...
Written By:
Carmen Leitch
MAR 08, 2024
Microbiology
Tens of thousands of people die from antibiotic resistant infections very year, and these pathogenic microbes present a
...
Written By:
Carmen Leitch
NOV 28, 2023
Cell & Molecular Biology
Scientists have discovered that a very common microbe that grows in many places, including human skin, can directly caus
...
Written By:
Carmen Leitch
JAN 29, 2023
Microbiology
We share the world, and our bodies with bacteria. Many of those microbes are harmless or even beneficial, while some can
...
Written By:
Carmen Leitch
DEC 09, 2022
Clinical & Molecular DX
Labroots’ virtual events are a fantastic way to network and learn about the work of other researchers in your fiel
...
Written By:
Laurence Tognetti, MSc
JUL 08, 2022
Immunology
Some common bacteria like Staphylococcus aureus have both harmless and pathogenic versions. While staph is often harmles
...
Written By:
Carmen Leitch
MAY 20, 2022
Microbiology
Bacteria live all around us, even in us. Though some bacterial pathogens can cause dangerous infections, many of those m
...
Written By:
Carmen Leitch
OCT 26, 2021
Microbiology
For many years, scientists and experts have warned about a building crisis - antibiotics are becoming less reliable, bac
...
Written By:
Carmen Leitch
OCT 20, 2021
Microbiology
Many animals, including humans and cats, harbor huge colonies of microbes, which may live in places like the skin, or th
...
Written By:
Carmen Leitch